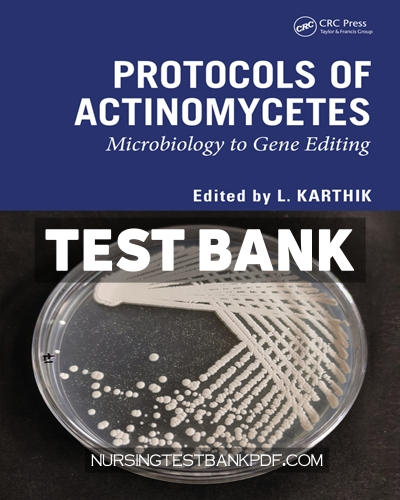
9781040225721-TEST-BANK Test Bank for Protocols of Actinomycetes 1st Edition by CRC Press

Test Bank for Bioremediation of Environmental Toxicants 1st Edition by CRC Press
$60.00 Original price was: $60.00.$29.00Current price is: $29.00.

Test Bank for Applied Health Humanities for the Aging 1st Edition by Stickle
$60.00 Original price was: $60.00.$29.00Current price is: $29.00.
Test Bank for Protocols of Actinomycetes 1st Edition by CRC Press
$60.00 Original price was: $60.00.$29.00Current price is: $29.00.
Complete test bank for protocols of actinomycetes 1st edition by crc press. All chapters are included. Instant download.
SKU:
9781040225721-TEST-BANK
Category: CRC Press Test Banks
Description
Downloadable test bank for protocols of actinomycetes 1st edition by crc press. All chapters are included. Instant download.
iSBN: 9781032504230,9781040225707,9781003398400,9781040225721.
Shipping & Delivery